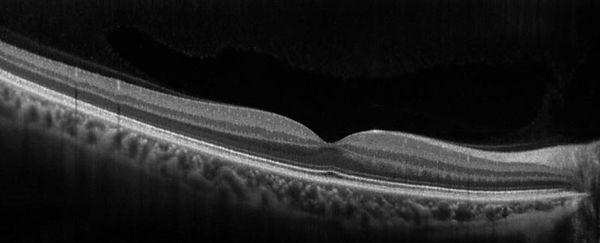
Oftalmología, oftalmólogo, oftalmóloga, centro de ojos, roca, general roca, glaucoma, presión ocular, ojo seco, nervio óptico

maculopatías
Membrana Epirretinal
.jpeg)
Foto de membrana epirretinal
.jpeg)
Foto de fondo de ojo normal

Estudio de OCT Macular: muestra alteración de la anatomía de la mácula por contracción de la membrana (línea blanca brillante)
Estudio de OCT ojo normal
¿Qué es una membrana epirretinal?
La membrana epirretinal (o membrana epimacular) es una enfermedad en la cual se forma una membrana sobre el area macular. Se encuentran en aproximadamente el 2 % de los mayores de 50 años y en el 20% de los de 75 años. Su evolución es habitualmente lenta. Su causa principal es la edad, aunque es frecuente observarla secundaria a:
-
Cirugía oculares previas.
-
Traumas oculares.
-
Enfermedades vasculares de la retina.
-
Inflamaciones intraoculares.
Sus síntomasprincipales son:
-
Deformación de las imágenes (se lo denomina: metamorfopsias).
-
Disminución de la visión de lejos y cerca.
-
Visión borrosa.
Su diagnóstico se realiza con un examen oftalmológico completo donde se incluya un fondo de ojo y la Tomografía de Coherencia Óptica (OCT).
El tratamiento se realiza con vitrectomía en la cual se realiza el pelaje de la membrana que será indicado en base a cada cuadro clínico.
¿Le quedan dudas?
¡Deje su consulta!

